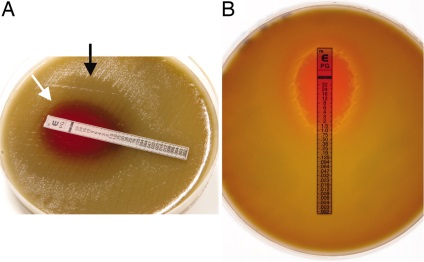

E-teszt (E-teszt)
E-teszt - értékelésére vonatkozó módszer a antibiotikum rezisztencia
E-teszt (E-teszt) - egy jól átgondolt módszer meghatározására antibiotikum érzékenységi laboratóriumokban világszerte. Széles körben használják a tanulmány a rezisztencia mind diagnosztikai és tesztelési klinikákon. A teszt egy mennyiségi meghatározására szolgáló eljárás a MIC a gombaellenes és baktériumellenes szerek fertőző ágensek, beleértve a szepszist, ami különösen fontos a kritikus állapotú betegek. Ebben az eljárásban, jelenleg több mint 100 antibiotikumok tesztelésére számos aerob baktériumok és érzékeny organizmusok, például pneumococcus, Haemophilus baktériumok, H. pylori, meningococcus, gonokokkuszt, anaerob, gombák és mycobacteriumok. E-teszt lehetővé teszi a racionális antibiotikumok alkalmazása, amelyek a legjobb eredményt a beteg, valamint a korrekció az empirikus kezelési után felírása. A teszt rendkívül fontos, hogy meghatározzuk azt a dózist az antibiotikum betegek nehezen topográfiailag lokalizált fertőzésgóc (nincs. Szívbelhártya-gyulladás), egyes kórházban szerzett fertőzések, valamint a krónikus fertőzések immunrendszerű betegeknél.
E-teszt - egy egyedülálló, szabadalmaztatott technika. Ennek lényegét abban áll, hogy a műanyag tesztcsík jelölt hígítássorozatát az antibiotikum a legkisebbtől a legnagyobbig, és pontosan határozza meg legalább 15 hígítású antimikrobiális aktivitásának érzékeny bakteriális ágensek, mint akár nem.
a vizsgálati eljárás egyszerű, a reagens csík kerül a felületére a beoltott agar-hígításos a szabvány. Az inkubálás után az eredmény leolvasható a lerakódott vízkő lemez hígításos helyén metszéspontjában növekedési gátlási zóna, ellipszis, a tesztcsík.
E-teszt számos előnye van a kontroll ellenállás, R. A. Ez tartalmaz egy koncentrációgradiens, amely megmutatja a legkisebb változás érzékenység. A szélessége E vizsgálat koncentrációgradiens kiterjed variációk érzékeny

Ez a legérzékenyebb teszt ma. E-teszt - az makrometod ami könnyen be a laboratóriumba az érzékenység. A korszak a felfedezés új fertőzések és a növekvő ellenállás a mikroorganizmusok antibiotikum, E-teszt világszerte elismert, mint a legfontosabb innováció meghatározó antimikrobiális aktivitást.
- antibakteriális
- gombaellenes
- tuberkulózis
- A meghatározása MDR

E-teszt amfotericin B AP-32 (F 30)

Fólia csomagolás egy (szekcionált műanyag csomagoló) 10 sejtek, mindegyik cella tartalmaz 3 csíkok (antibakteriális). Tárolás -20 ° C-on
